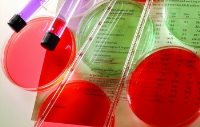

Устройство для восстановления простейших зрительных навыков, названное Argus II, уже получило одобрение на продажи на территории Евросоюза. Испытания были проведены на более чем 50 пациентах, многие из которых получили способность различать цвета, движения и объекты.
Прибор представляет из себя ...
Подробнее »